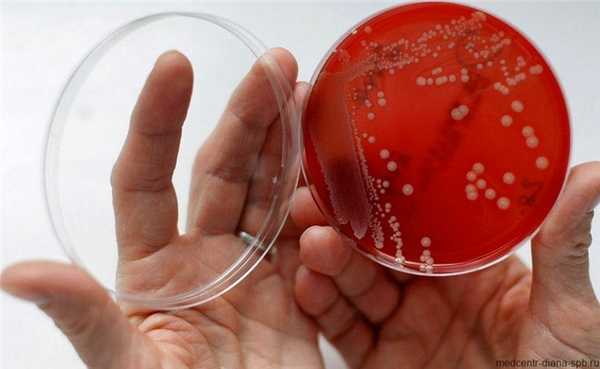
Гарднереллез: причины заболевания, диагностика, последствия и лечение

Диагностика гардренелл. Микробиологическая диагностика гардренеллеза. Лечение гардренеллеза.
Добавил пользователь Алексей Ф. Обновлено: 11.12.2025
Гарднереллез и молочницу относят к самым распространенным инфекционным заболеваниям женской половой сферы. Виновники нарушений микрофлоры влагалища — два вида возбудителей: бактерия гарднерелла (Gardnerella) и грибковый агент кандида (Candida).
Хотя прямая связь между бактерией и грибком отсутствует, в микрофлоре возбудители обычно присутствуют вместе. Патогенные микроорганизмы приводят к развитию разных заболеваний, которые отличаются особенностями протекания, а также методами лечения.
Причины активности гарднереллы и молочницы
Вредоносные микроорганизмы относятся к представителям условно-патогенной микрофлоры, постоянно присутствующим на слизистых оболочках мужчин и женщин со здоровым иммунитетом, но в малых количествах. В случае нарушения иммунной защиты колонии патогенов стремительно растут, что приводит к развитию воспалительных заболеваний.
Характерные причины гарднереллеза и молочницы:
- частая смена половых партнеров, что касается не только мужчин, но и женщин;
- редкая замена женщинами гигиенических прокладок, особенно во время месячных;
- естественные сбои гормонального равновесия (беременность, климакс):
- продолжительная терапия гормональными препаратами;
- недолеченный дисбактериоз по причине длительного лечения антибиотиками;
- ношение неудачно подобранного белья – слишком тесного или синтетического;
- предрасположенность к аллергии, избыток токсических веществ в организме.
Важно. Одна из главных причин увеличения популяции гарднереллы и кандиды связана с пренебрежительным отношением к правилам личной гигиены. Вред приносит не только слишком редкое выполнение гигиенических процедур. Чрезмерное увлечение спринцеваниями приводит к вымыванию дружественной микрофлоры, создавая благоприятные условия для стремительного размножения патогенов.
Что представляют собой гарднереллез и кандидоз
Эти половые инфекции, схожие по причинам развития и симптоматике, не относятся к числу венерических заболеваний, но не менее . При отсутствии своевременного лечения гарднереллы и молочницы патология превращается в хронический процесс, на избавление от которого потребуется немало усилий и времени.
Почему развивается гарднерелла и откуда появляется?
Гарднереллы проникают в организм здоровой женщины в результате полового контакта, но при низкой концентрации бактерий не причиняют вреда. Когда иммунитет слабеет, начинается стремительный рост колоний гарднереллы. Это приводит к развитию воспалительного заболевания мочеполовой сферы, возбудитель которого подавляет полезную микрофлору, открывая дорогу другим видам инфекций.
Другими причинами начала гарднереллеза могут выступать следующие факторы:
- спринцевания антисептиками с хлором (Мирамистин);
- противозачаточная терапия препаратами с 9-ноноксинолом (Ноноксинол);
- применение влагалищных суппозиториев типа Полижинакс.
В случае попадания возбудителя в организм при половом акте либо контактным путем, продолжительность инкубационного периода составит 1-2 недели. Если болезнь стала результатом сниженного иммунитета, об инкубационном периоде речь не идет. Поэтому важно знать симптомы гарднереллы, чтобы быстрее обратиться к врачу.
Симптомы влагалищного гарднереллеза
Сигналы инфицирования проявляются не сразу, на рост концентрации бактерий во влагалище уходит 3-10 суток. Затем клиническая картина гарднереллеза сигнализирует следующими проявлениями:
- увеличением объема выделений из влагалища, имеющих пенистую структуру вместе с желтовато-сероватым оттенком;
- усилением болезненных ощущений по низу живота на фоне развития симптомов, характерных для простуды;
- нарастающим жжением во влагалище, зудом как при молочнице, учащением позывов к мочеиспусканию;
- усилением болезненных всплесков на фоне неприятных ощущений по ходу полового акта либо выхода мочи.
Рост популяции гарднереллы и кандиды сопровождается появлением плохого запаха в области половых путей. Женщина жалуется на стойкую и резкую зловонность, которая свидетельствует о разложении продуктов жизнедеятельности возбудителей. Присутствие дурного запаха также указывает на быстрое размножение патогенов.
Внимание. Признаки гарднереллы и симптомы молочницы у беременных женщин могут стать причиной преждевременных родов или выкидыша, вызвать падение веса плода, развитие послеродовых патологий.
Что такое молочница?
Молочницей называют проявления вагинального кандидоза, вызванного колонизацией слизистой влагалища грибками дрожжевого типа – кандида. Результатом становится нарастание воспалительного процесса в стенках влагалища. Заболевание развивается по сценарию двух клинических форм:
- этап острого воспаления;
- фаза ярко выраженных клинических симптомов.
Для каждой клинической формы характерны определенные методы лечения после проведения определенных диагностических мероприятий. Спровоцировать появление молочницы способны обострения эндокринных либо мочеполовых заболеваний, частые стрессовые ситуации, наступление беременности либо менопаузы, увлечение монодиетами.
Схожесть симптомов и диагностика
Женщины, которые сталкивались с проявлениями молочницы или гарднереллы, часто страдают от сочетания бактериальной и грибковой инфекции. Причины возникновения вагинального кандидоза вместе с его симптомами аналогичны присутствию гарднереллы, но гарднерелла – это вовсе не молочница.
Поскольку возбудителем кандидоза являются не бактерии, а дрожжевые грибки, то и диагностика инфекций проводится неодинаковыми методами:
- Для выявления гарднереллы выполняется исследование секрета, взятого из влагалища. Задача диагностики не обнаружение, а обнаружение конкретного количества патогенов.
- Грибковую инфекцию диагностируют путем взятия мазка со слизистой влагалища, а также шейки матки.
Забор материала производится по ходу гинекологического осмотра.
В некоторых случаях врачу могут потребоваться результаты ПЦР-анализа, а также данные бакпосева для уточнения диагноза и назначения правильной схемы лечения.
Лечение заболеваний
Без квалифицированного лечения молочница у женщин рискует превратиться в хроническую патологию с периодическим нарастанием и исчезновением симптомов. Повышенная концентрация гарднереллы во влагалищной микрофлоре неминуемо оборачивается воспалением с развитием дисбактериоза.
Лечение грибковой инфекции осуществляется назначением противогрибковых препаратов в комбинации с орошением отекших тканей влагалища растворами антисептиков. При комбинированном варианте инфицирование актуально применение Хлоргексидина, свечей либо вагинальных таблеток на его основе. Выбор конкретного препарата против кандид выполняется на основе результата бакпосева, проявляющего чувствительность грибка в отношении конкретного вещества.
Терапию гарднереллы выполняют антибиотиками (Метронидазол, Клиндамицин). Лечебный процесс завершают препаратами для восстановления влагалищной микрофлоры, а также назначением общеукрепляющих средств, повышающих иммунитет.
К сведению. Традиционные методы лечения гарднереллы и молочницы у женщин не запрещено сочетать с применением народной терапии – орошение влагалища отварами противовоспалительных трав, закладывание тампонов с облепиховым маслом.
Профилактические меры
Грибки Candida так же, как и Gardnerella, в небольшой концентрации присутствуют на слизистых человека. Для защиты от угрозы повышения их концентрации, предотвращения развития заболевания на 90% следует обезопасить себя от влияния провоцирующих факторов:
- незащищенных контактов со случайными половыми партнерами;
- пренебрежения правилами личной (интимной) гигиены;
- неправильного питания, следования вредным привычкам;
- заражения половыми инфекциями, в том числе экстрагенитальными;
- отрицательного влияния стрессовых ситуаций, конфликтов.
Не менее важным аспектом профилактики гарднереллы и молочницы должна стать защита от переохлаждений или перегрева. Факт несвоевременного или неполного лечения половых инфекций пагубно отражается на иммунных способностях человека.
Подключение к рациону питания продуктов кисломолочного ряда и витаминных комплексов необходимо для поддержания баланса полезной микрофлоры, что снижает риск кандидоза. Пренебрежение правилами комплексной профилактики оборачивается превращением гарднереллеза и кандидоза в хроническую патологию, которую легче предупредить, чем вылечить навсегда.
Гарднереллез
Гарднереллез – вагинальный дисбактериоз, связанный с резким количественным и качественным нарушением нормальной микрофлоры влагалища, снижением количества лактобактерий и размножением условно-патогенных микроорганизмов, в т. ч. гарднереллы. Характеризуется появлением обильных влагалищных выделений сероватого оттенка с неприятным запахом. Нелеченные бактериальные вагинозы повышают риск развития воспалительных заболеваний женской половой сферы и невынашивания беременности.
Общие сведения
Гарднереллез является наиболее частым вариантом бактериального вагиноза, т. е. нарушения баланса в составе естественной микрофлоры женских половых органов. Гарднереллез наблюдается у 20% женщин в репродуктивном периоде. Молочнокислая микрофлора, в норме преобладающая во влагалище, при бактериальном вагинозе вытесняется условно-патогенными видами, лидером среди которых является гарднерелла. Путь передачи гарднереллеза - половой, чаще гарднерелла выявляется у женщин активных в сексуальной жизни. Мужчины обычно выступают в роли носителей инфекции, поэтому, чтобы исключить рецидивы гарднереллеза, следует осуществлять одновременное лечение всех половых партнеров.
Гарднереллез в запущенной форме может вызывать развитие воспаления мочевых путей, матки и придатков, бесплодию, осложнениям во время беременности и родов. При гарднереллезе часто отмечается смешанное инфицирование с другими микроорганизмами: гонококками, трихомонадами, микоплазмами, хламидиями, кандидами и т. д.
Причины гарднереллеза
Бактериальный вагиноз (гарднереллез) возникает как дисбаланс в составе естественной микрофлоры влагалища, когда начинают доминировать «нефизиологичные» виды микроорганизмов, в первую очередь, гарднерелла. Нарушать нормальную микрофлору мочеполовых органов могут внешние и внутренние факторы.
Среди внешних факторов, обусловливающих развитие гарднереллеза, преобладают:
- неблагоприятная экология;
- недавняя и частая смена полового партнера;
- нерациональное питание, диеты с недостатком молочно-кислых продуктов;
- венерические заболевания;
- применение антибиотиков (в том числе свечи, мази);
- применение противозачаточных средств (вагинальных свечей, содержащих 9-ноноксинол, презервативов со спермицидной смазкой, гормональных препаратов);
- использование гигиенических средств (прокладок, тампонов, парфюмированных средств интимной гигиены) и частое спринцевание;
- ношение белья и одежды из синтетических материалов, плотно облегающих фигуру.
К внутренним факторам, вызывающим гарднереллез, относятся:
- эндокринные нарушения и изменения (в том числе беременность);
- снижение уровня иммунной защиты, иммунодефицитные состояния;
- эмоциональное и физическое переутомление, стресс;
- хронические заболевания, дисбаланс микрофлоры кишечного и мочеполового тракта.
Патогенез
В норме во влагалище у взрослой женщины обнаруживается более 15 видов микроорганизмов. Преобладают ацидофильные лактобактерии, меньшую часть составляют бифидобактерии (10%), пептострептококки (~ 5%). Лактофлора благодаря молочной кислоте поддерживает кислую среду слизистой гениталий, которая выполняет местную защитную и иммунную функции.
В малых количествах во влагалище женщин встречаются анаэробные бактерии (мобилункус, бактероиды, гарднерелла и др.), генитальные микоплазмы, трихомонады, кандиды. Резкое увеличение численности этих микроорганизмов нарушает микробиологическое равновесие, возникает дисбактериоз влагалища или бактериальный вагиноз. Он характеризуется уменьшением количества микрофлоры Додерляйна (лактобактерий) и преобладанием условно-патогенных видов. Чаще других у женщин с бактериальным вагинозом обнаруживают вагинальную гарднереллу, являющуюся основной, хотя и не единственной причиной этих нарушений. Поэтому состояние бактериального вагиноза называют гарднереллез.
Кроме гарднерелл увеличивается количество других бактерий (кокковые виды, трихомонады, микоплазмы, мобилункус, дрожжеподобные грибки). Роль гарднереллы в развитии бактериального вагиноза состоит в том, что она создаёт благоприятный фон для размножения условно-патогенных и патогенных микроорганизмов. Влагалищная среда защелачивается, продукты обмена гарднерелл усугубляют возникшие нарушения слизистой, возникает основа для проникновения других инфекций. Поэтому гарднереллез способствует развитию воспалительных заболеваний мочеполовой системы женщин.
Симптомы гарднереллеза
Гарднереллез имеет течение, несколько сходное с другими воспалительными заболеваниями гениталий у женщин. При гарднереллезе наблюдаются: сероватые выделения из влагалища (однородные, пастообразные, с неприятным «рыбным» запахом); жжение, зуд, дискомфорт при мочеиспускании и половом контакте. Гарднереллез сопровождается воспалительными изменениями во влагалище, уретре и шейке матки. При использовании внутриматочных спиралей, после месячных, прерываний беременности и родов гарднереллез может осложниться эндометритом, воспалением придатков матки. Гарднереллез неблагоприятно воздействует на беременность: чаще наблюдаются преждевременные роды, дети рождаются ослабленными, недоношенными, возможно инфицирование плода в родах.
Наличие гарднерелл в урогенитальном тракте мужчин, в большинстве случаев, никак не проявляется, изредка вызывает вялотекущий воспалительный процесс с признаками уретрита. Тогда могут появляться небольшие выделения из уретры (серозно-гнойные, сероватого цвета с «рыбным» запахом), дискомфорт при мочеиспускании. Возможны осложнения в виде простатита, воспаления яичек и придатков, развития бесплодия.
Диагностика
Для подтверждения диагноза гарднереллеза на консультации гинеколога у женщины берут мазки из влагалища. В диагностике гарднереллеза значение имеет не столько наличие гарднерелл, сколько их количество и соотношение микроорганизмов в составе влагалищного секрета. Гарднереллы присутствуют во влагалищной флоре большинства здоровых женщин без развития дисбактериоза. Диагноз «гарднереллез» устанавливается на основании:
- жалоб пациенток и клинических проявлений (наличие однородных пастообразных выделений серовато-белого цвета);
- увеличения РН секрета влагалища (> 4,5);
- присутствия «ключевых» клеток в микроскопии мазков из влагалища и уретры («ключевые клетки» - эпителиальные клетки, облепленные мелкими палочками (гарднереллами) - важный признак гарднереллеза);
- аминового теста
При гарднереллезе, в процессе своей жизнедеятельности, гарднереллы и анаэробные микроорганизмы образуются летучие амины (путресцин, триэтиламин, кадаверин), которые при распаде дают неприятный «рыбный» запах. Основанием для постановки диагноза гарднереллеза служит обнаружение как минимум трёх из этих критериев. Также необходимо обследоваться на наличие дисбактериоза кишечника, который может провоцировать развитие бактериального вагиноза, и провести его лечение. Это снизит риск рецидивов гарднереллеза.
Лечение гарднереллеза
Ранняя и точная диагностика гарднереллеза позволяет своевременно провести его лечение. Методы терапии, которые применяет современная гинекология, позволяют добиться выздоровления пациентки и избежать развития осложнений, но не гарантируют отсутствие рецидивов заболевания в будущем. Терапевтическое лечение гарднереллеза должно ликвидировать причины и проявления заболевания и создать условия для нормализации микрофлоры половых органов.
На первом этапе лечения гарднереллеза женщинам назначают препараты клиндамицина и метронидазола (перорально и интравагинально): клиндамицина фосфат – капсулы и вагинальный крем (2%); метронидазол – таблетки и гель (0,75%). Чтобы избежать развития вагинального кандидоза при лечении гарднереллеза, назначают клотримоксазол (крем). При ведении беременности у женщин, страдающих гарднереллезом, лечение начинают во втором триместре беременности этими же препаратами (внутрь и местно по назначению врача). В первом триместре пероральное применение метронидазола и клиндамицина недопустимо.
Лечение гарднереллеза проводится под контролем клинико-лабораторных анализов, и считается оконченным при исчезновении жалоб, симптомов и нормализации лабораторных критериев. Во время лечения гарднереллеза необходимо избегать половых контактов без презерватива, отказаться от спиртных напитков, не использовать прокладки на «каждый» день, тесное синтетическое бельё. Второй этап лечения гарднереллеза включает применение внутрь и местно препаратов, содержащих лакто- и бифидумбактерии, витаминов, иммуностимуляторов.
Необходимость обследования и лечения мужчин - половых партнеров женщин, больных гарднереллезом, остаётся дискуссионной. Рецидивы гарднереллеза у женщин могут возникать и после лечения обоих половых партнёров. Всё же, целесообразно при упорных и рецидивирующих случаях гарднереллеза проводить такое лечение и у представителей сильного пола.
Профилактика гарднереллеза
Избежать развития гарднереллеза и его рецидивов помогут профилактические меры, направленные на устранение причин возникновения бактериального вагиноза. Широкая распространенность и опасность последствий гарднереллеза требуют не только немедленного лечения заболевания, но и его регулярной бытовой и медицинской профилактики. Женщинам рекомендуется:
Гарднереллез: причины заболевания, диагностика, последствия и лечение
Гарднереллез заболевание вызванное превышением содержания бактерии гарднерелла вагиналис в микрофлоре влагалища. Болезнь не является венерической и в большинстве случаев вызывается сбоями внутренних процессов организма, или внешними факторами, провоцирующими дисбактериоз микрофлоры.
Прием УРОЛОГА — 1000 руб. Консультация врача (вторичный прием) по результатам анализов или УЗИ — 500 руб.
Заболевание свойственно для женщин, так как гарднерелла – бактерия, обитающая в микрофлоре слизистых тканей влагалища. Однако при половом контакте бактерии могут передаваться и мужчинам. Если мужчина полностью здоров, попадание бактерий в большинстве случаев не несет существенных рисков.

Бактерия гарднерелла была выявлена только в 1955 году, на данный момент разработаны эффективные препараты, способствующие ее уничтожению и стабилизации состояния микрофлоры. Но, от появления гарднереллеза не застрахован никто, а само заболевание способно доставить как ощутимый дискомфорт, так и нанести существенный вред здоровью, если вовремя не приняты необходимые меры.
Что такое бактерия Гарднерелла вагиналис
Гарднерелла вагиналис – коккобацилла из семейства условно-патогенных микроорганизмов. В минимальных количествах всегда присутствует среди прочих бактерий составляющих микрофлору влагалища. При создании приемлемых условий для размножения, начинает агрессивное деление, попутно, уничтожая полезные бактерии составляющие основу здоровой микрофлоры. Способна сохранять жизнедеятельность в выделениях до 6 часов, в виде спор жизнеспособна до 1 года.
Несмотря на агрессивный характер бациллы, ее присутствие во флоре в допустимых показателях не имеет рисков и напротив, способствует нормализации показателей кислотности и прочих параметров среды. Но при превышении показателей, требуется незамедлительное лечение.
Риски и проявление Гарднереллеза
При содержании гарднереллы в количествах сопоставимых с допустимой нормой, не обнаруживается каких-либо негативных симптомов, болевых проявлений и прочих недостатков. Однако при значительном увеличении количества микроорганизмов, могут проявляться следующие симптомы:
- Появляется неприятный запах выделений, схожий с запахом тухлой рыбы;
- При острых стадиях наблюдается помутнение и изменение цвета выделений влагалища;
- Ухудшение работы иммунной системы, частые простудные, воспалительные заболевания;
- Нарушение флоры слизистой кишечника, сопровождаемые неприятными ощущениями, изменением стула (острая форма заболевания).
Разрушительный эффект от бактерии гарднерелла вагиналис проявляется в том, что бациллы повреждают эпителиальные ткани слизистой оболочки и провоцируют растворение фагоцитов исполняющих в организме роль барьера для патогенных микроорганизмов.
Дисбактериоз влагалища вызванный гарднереллой способен перерасти в инфекцию мочеполовой системы, в случае если не приняты своевременные меры. Также гарднереллез может стать причиной воспалительного вагинита, при котором наблюдаются неприятные ощущения, боль и жжение в процессе мочеиспускания. При появлении данных симптомов незамедлительно следует обратиться к специалисту.
Гарднереллез во время беременности
Наибольшую опасность представляет резкое обострение гарднереллеза во время беременности. Как показывает статистика, патология встречается приблизительно у 20% женщин в период беременности. Благодаря естественным защитным механизмам организма, активно стимулируемым в период беременности, часто инфекционные процессы на начальных этапах подавляются иммунной системой организма. Однако, если иммунитет ослаблен, может наблюдаться развитие заболевание, что в дальнейшем может иметь следующие негативные последствия:
- Осложненная беременность;
- Повышение или понижение тонуса матки;
- Поражение околоплодной жидкости бактериями гарднереллы;
- Преждевременные роды.
Учитывая все риски, при планировании беременности, а также в период вынашивания ребенка, стоит регулярно сдавать анализы на гарднереллез и прочие патогенные микроорганизмы, способные вызывать дисбактериоз влагалища и др. осложнения.
Также, стоит помнить о том, что гарднереллез может передаться от матери ребенку (девочке) во время родов. Поэтому стоит крайне внимательно следить за собственным здоровьем и вовремя принимать необходимые меры.
Как выявляется и диагностируется гарднереллез
Выявление заболевания производится в процессе исследования взятых на анализ биоматериалов пациента. В частности при обследовании у гинеколога или лечащего врача, может потребоваться сдать следующие анализы:
- Мазок со слизистых оболочек стенок влагалища и шейки матки;
- Анализ мочи при подозрении на инфицирование мочеполовой системы и протоков.

При получении анализа обратите внимание на следующие показатели
Тип анализа
Показатели нормы
Отклонения от нормы
Содержание бактерий гарднереллы меньше 1000 КОЕ в 1 мл мочи
Содержание бактерий гарднереллы больше 1000 КОЕ в 1 мл мочи
Содержание бактерий гарднереллы до 10 в 5 степени от общего объема микроорганизмов.
Содержание бактерий гарднереллы свыше 10 в 5 степени от общего объема микроорганизмов.
Для повышения точности диагностирования рекомендуется сделать анализ мазка и мочи одновременно. Если содержание бактерий в пределах нормы, но наблюдаются симптомы гарднереллеза, рекомендуется произвести повторный анализ через неделю после первого, чтобы дать бактериям период для развития и увеличения численности.
Причины появления гарднереллеза
Гарднереллез в большинстве случаев провоцируется внешними факторами либо активизируется в ходе каких-либо заболеваний способных повлиять на баланс флоры влагалища. Среди причин способных спровоцировать развитие заболевания, специалисты называют следующие факторы:
- Инфекционные половыезаболевания – при венерических заболеваниях, сопутствующим осложнением является дисбактериоз флоры влагалища, в результате которого может наблюдаться резкое увеличение количества бактерий гарднереллы;
- Несоблюдение правил интимной гигиены – регулярное использование ежедневных прокладок может повлиять на состояние микрофлоры. Несвоевременная замена средств личной гигиены во время месячных, также может привести к появлению дисбактериоза;
- Гормональные нарушения – гормональный сбой провоцирует изменения во флоре слизистых тканей нарушая баланс микроорганизмов. Гормональные сбои могут быть вызваны различными заболеваниями или целенаправленным приемом гормоносодержащих препаратов при лечении;
- Прием лекарственных препаратов – различные антибиотики, используемые для лечения инфекционных заболеваний, могут действовать на флору влагалища, снижая количество полезных бактерий и провоцируя дисбактериоз. То же касается различных средств контрацепции, противозачаточных таблеток , оральных презервативов;
- Дисбактериоз кишечника – нарушения флоры кишечника способны стать катализатором дисбактериоза влагалища;
- Неразборчивость в интимных отношениях, частая смена партнеров;
- Снижение иммунитета на фоне различных заболеваний или общего ослабления организма в зимний период, авитаминоз и т.д.;
- Проведение операций, инвазивных косметологических процедур способных отразиться на балансе микроорганизмов.
Причин, по которым может начаться гарднереллез достаточно много. Но если соблюдать правила личной, интимной гигиены, обращаться вовремя к врачу и лечить вирусные и инфекционные заболевания, не давая им перейти в затяжное или хроническое состояние, то можно защитить себя от этой неприятной болезни.
Гарднереллез у мужчин
Гарднереллия – бактерия, которая не может появиться в организме мужчины самостоятельно, но, ее можно получить во время незащищенного полового акта с зараженной женщиной. Для мужчин заражение гарднереллией не так страшно, так как если организм здоров и не имеется вирусных заболеваний или сильного ослабления иммунитета, скорее всего бактерии погибнут и будут выведены естественным путем.
В случае если организм ослаблен, бактерия может стать причиной уретрита и доставить значительный дискомфорт. Заболевание проявляется дискомфортом, жжением и резью в процессе мочеиспускания. Однако если обратиться к врачу, заболевание лечится быстро и без последствий. Стоит помнить о том, что мужчина может выступать в качестве переносчика гарднереллий и если у женщины наблюдаются частые рецидивы после лечения гарднереллеза, тогда стоит провериться и мужчине на факт наличия микроорганизмов в мочеполовой системе. Сделать это можно обратившись к урологу, потребуется сдать мазок и анализ мочи.
К какому специалисту обратиться для лечения гарднереллеза
Гарднереллез не является венерическим заболеванием. А значит, при появлении симптоматики, следует обратиться к гинекологу, который проведет первичный осмотр, возьмет мазок для анализа. Если ход болезни сопровождается расстройством кишечника, стоит обратиться и к гастроэнтерологу, так как гарднереллез может быть причиной дисбактериоза кишечника. Мужчины с гарднереллезом должны обратиться к урологу.
Если есть подозрения, что половой партнер также является носителем бактерий гарднеллеры, то мужчине стоит пройти осмотр у уролога и также сдать необходимые анализы для выявления патогенных бактерий.
Грандереллез вполне поддается лечению и нормализовать микрофлору можно в течении 1,5-2 недель в зависимости от запущенности случая и индивидуальных особенностей. Лечение проходит в два основных этапа:
- Прием антибиотиков для уничтожения бактерий гарднереллы. Антибиотики подбираются специалистом. При выборе учитываются индивидуальные противопоказания, эффективность того или иного препарата, а также общее состояние здоровья. Не стоит самостоятельно принимать какие-либо препараты, обязательно обратитесь к врачу. Специалист может назначить антибиотические препараты различного типа. Для повышения эффективности используются антибиотики местного действия в форме вагинальных свечей. В зависимости от запущенности случая могут быть назначены и таблетки. Важным моментом, является тот факт, что при приеме антибиотиков, может развиться молочница и специалист, учитывая это, пропишет свечи для ее предотвращения;
- На втором этапевосстанавливается микрофлора. Для этого во влагалище заселяются колонии лактобактерий нормализующих среду и восстанавливающих состояние слизистых оболочек. Прописываются свечи или спринцевания, которые также может назначить специалист. Второй этап начинается только после успешного уничтожения гарденереллей, после курса антибиотиков потребуется сдать необходимые анализы.
В процессе лечения, специалист пропишет диету, которая будет способствовать стабилизации флоры. В частности рекомендуется употребление молочнокислых продуктов, кефира, биокефира, йогуртов и т.д.
Строго рекомендуется ограничить употребление:
- Острой пищи;
- Жареной пищи;
- Алкоголя и табака.
Также врач может назначить препараты для повышения иммунитета. Ведь ослабленная иммунная система не в состоянии бороться с инфекциями и воспалениями.
В течении всего периода лечения стоит воздержаться от интимной близости и попросить партнера также сдать анализы и проверится на наличие бактерий. Мужчина может выступать переносчиком и после лечения вполне можно заразиться вновь.
По окончанию курса лечения сдаются повторные анализы, контрольный мазок делается через 2 месяца. В большинстве случаев медикаментозное лечение позволяет полностью избавиться от проблемы. Для профилактики заболевания в дальнейшем стоит внимательно относиться к личной интимной гигиене, отдавать предпочтение белью из натуральных материалов и ежегодно сдавать анализы на патогенную микрофлору. При первых признаках заболевания, неприятных ощущения, изменении цвета или запаха выделений нужно сразу обращаться к гинекологу.
Где вылечить гарднереллез в СПБ
Лечение инфекций в Санкт-Петербурге проводится в клинике Диана. Вы можете записаться на анализы и консультацию уролога или гинеколога анонимно.
Лечение гарднереллы у женщин
Гарднереллы (Gardnerella vaginalis) – это анаэробные бактерии, которые входят в состав нормальной микрофлоры влагалища. В организме здоровой женщины эти бактерии не вызывают патологических реакций. Однако если в микрофлоре влагалища уменьшается количество лактобактерий, развивается воспалительный процесс половых органов – гарднереллез.

Лечение гарднереллы у женщин
Лечение гарднереллы вагиналис у женщин назначает врач гинеколог. Самолечение может быть опасно для здоровья. Эффективную диагностику и лечение уреаплазмы, микоплазмы и гарднереллы у женщин в Санкт-Петербурге проводят врачи современного медицинского центра «Диана».
Лечение гарднереллы у женщин: причины развития заболевания
Гарднереллез не относится к венерическим заболеваниям. Его основной причиной становится снижение количества лактобактерий в микрофлоре влагалища. В норме лактобактерии вырабатывают молочную кислоту, отвечающую за создание кислой реакции вагинальной среды (рН < 7). Это позволяет удерживать рост колоний условно-патогенных бактерий. Если численность лактобацилл сокращается, бактерии Gardnerella vaginalis начинают активно размножаться, вызывая воспалительные процессы.
Не существует одной причины уменьшения лактобацилл в микрофлоре влагалища. К наиболее вероятным провоцирующим факторам относят:
- Частая смена половых партнеров . Точный механизм не установлен, но доказано, что женщины ведущие беспорядочную половую жизнь чаще страдают гарднереллезом.
- Незащищенный секс . Если семяизвержение регулярно происходит во влагалище, высок риск защелачивание слизистой оболочки. Это способствует размножению Gardnerella vaginalis.
- Хронические воспаления половых путей . В зонах воспаления меняется нормальная микрофлора, что приводит к активации условно-патогенных бактерий.
- Длительное лечение антибиотиками . Антибактериальные препараты подавляют всю флору, в том числе и лактобациллы. . Эндокринные заболевания могут оказывать влияние на чувствительность организма к росту колоний гарднерелл.
- Неправильное питание . Полный отказ от употребления кисломолочных продуктов может снижать численность лактобактерий влагалища.
Врач, проводящий лечение, не всегда может ответить на вопрос, откуда берется гарднерелла у женщин. Спровоцировать развитие заболевания может даже незначительное снижение иммунитета, тяжелые физические нагрузки, стрессы, заражения ИППП.
При каких симптомах гарднереллы у женщин нужно начать лечение?
Гарднереллез врачи не считают воспалительным заболеванием. Его развитие не всегда проявляется характерными симптомами. Заметить гарднереллез на ранней стадии можно только внимательно относясь ко всем изменениям в организме.
Причинами для обращения к гинекологу и начала лечения гарднереллы у женщин врачи считают появление таких симптомов:
- обильные белые, серые, зеленоватые влагалищные выделения;
- неприятный запах выделений, напоминающий запах тухлой рыбы;
- дискомфорт, зуд, жжение, боль в области влагалища;
- отек, покраснение наружных половых органов;
- тянущие боли внизу живота;
- н арушения мочеиспускания.
Самым характерным для гарднереллеза признаком считается именно запах тухлой рыбы, исходящий от половых органов и выделений. Этот симптом указывает на бактериальную природу патологии.
Зачем проводить лечение гарднереллы у женщин?
Некоторые люди считают, что если у женщин обнаружены гарднереллы, лечение проводить необязательно. На самом же деле гарднереллез может стать причиной опасных последствий для здоровья женщины. Заболевание может вызвать такие осложнения:
- воспаления органов малого таза (влагалища, шейки матки, матки, яичников, тканей брюшной полости);
- уретральный синдром (поражения тканей мочеиспускательного канала);
- эндометрит;
- внутриэпителиальная цервикальная неоплазия;
- в оспаления и абсцесс бартолиновой железы;
- нарушения репродуктивной функции (бесплодие).
Очень опасно заболевание во время беременности. По статистике с гарднереллезом сталкивается каждая третья будущая мама. Это может приводить к тяжелым патологиям плода. Такие дети часто рождаются с очень низким весом. Лечение гарднереллы у женщин при беременности проводится только при помощи местных препаратов. Прием антибиотиков, к которым чувствительны бактерии, в виде таблеток и уколов во время вынашивания ребенка нежелателен.
Лечение заболеваний гарднереллы у женщин
Терапия должна проводиться только после тщательной диагностики. Подтвердить диагноз позволяют такие анализы:
- микроскопическое исследование мазка на флору;
- оценка кислотно-щелочного баланса влагалищных выделений;
- анализ на инфекции, передающиеся половым путем.
Для определения чувствительности бактерий к антибиотикам дополнительно обязательно проводят бактериологический посев мазка на питательную среду. Это позволяет выбрать эффективную схему терапии.
Ведущее направление лечения гарднереллы у женщин – прием антибиотиков. Антибактериальные препараты могут быть назначены в виде уколов, таблеток и местных средств (свечи, мази, тампоны). Наибольшей эффективностью обладают противомикробные и антипротозойные средства.
В качестве дополнения к основной терапии, пациентке необходимо применять антисептические средства (хлоргексидин). На протяжении всего периода лечения важно соблюдать интимную гигиену, правильно питаться и укреплять иммунитет. Укрепление защитных сил организма существенно повышает эффективность терапии.
Еще один важный аспект лечения гарднереллы у женщин – назначение препаратов, содержащих молочную кислоту. Именно это вещество отвечает за создание кислой среды во влагалище и подавление патологического роста микрофлоры. Препараты с молочной кислотой назначают как в форме таблеток, так и в виде свечей.
Вылечиться от гарднереллеза народными способами нельзя. Многие непрофессиональные советы в интернете могут привести к усугублению последствий заболевания. Пройти эффективный и безопасный курс лечения в Санкт-Петербурге можно в медицинском центре «Диана» на Заневском проспекте. Врачи клиники обладают огромным опытом терапии гарднереллеза, в том числе на разных сроках беременности.
Гарднерелла вагиналис
Гарднерелла вагиналис (Gardnerella vaginalis) – анаэробная бактерия.
Он является основным возбудителем бактериального вагиноза у женщин и гарднереллеза у мужчин.
Поговорим о том, что за инфекция и чем опасна.
Отзывы пациентов говорят о том, что избавиться от патологии, вызванной гарднереллой, бывает очень трудно.
Гарднерелла как передается
Чтобы защититься от гарднерелл, важно знать, откуда берется этот микроорганизм.
Можно ли заразиться этим заболеванием от партнера или же оно развивается само по себе?
Бактерия живет только в урогенитальном тракте.
Её нет ни во рту, ни в прямой кишке, ни в каких-либо других участках организма.
Называется она гарднерелла вагиналис как раз по той причине, что обитает в женском влагалище.
У большинства женщин они определяются в тех или иных количествах.
Впервые гарднереллы могут попасть в половые органы от мужчин во время секса.
Изредка возможны другие пути заражения.
Например, использование совместно средств гигиены с другой женщиной, страдающей бактериальным вагинозом.
Часто спрашивают, передается ли через оральный секс гарднерелла и через поцелуй (слюну).
Такой способ заражения невозможен.
Потому что гарднереллы не живут во рту.
Они не определяются в слюне.
Соответственно, ни после орального секса, ни тем более после поцелуя заболеть нельзя.
У большинства женщин гарднерелла не вызывает никаких симптомов.
Её количество очень маленькое.
Иммунитет не воспринимает гарднереллу как патогенный микроорганизм и не атакует.
Поэтому воспалительная реакция не развивается даже при большом количестве этих микроорганизмов.
В норме во влагалище женщины микрофлора на 95% состоит из лактобактерий.
Они продуцируют молочную кислоту.
Поддерживая кислую реакцию во влагалище, тем самым лактобактерии создают неблагоприятные условия для других бактерий.
В том числе – для гарднерелл.
Но в силу определенных причин количество лактобактерий может снизиться.
После этого уменьшается продукция лизоцима, молочной кислоты и перекиси водорода.
В результате меняется рН влагалища в щелочную сторону.
Уменьшается противомикробная активность влагалищного секрета.
Это приводит к тому, что другие микроорганизмы начинают активно развивается.
Одним из основных является гарднерелла.
Она способна быстро вытеснять лактобактерии и замещать их.
Почему происходит первичное угнетение роста лактобактерий и изменение биоценоза влагалища?
На это есть множество причин.
Состав микрофлоры зависит от множества внешних и внутренних факторов, таких как:
- гормональный фон
- период полового созревания, беременность, климакс

- применение различных препаратов
- хирургические операции и т.д.
Из препаратов спровоцировать гарднереллез могут антибиотики или глюкокортикоиды.
Нередко женщины бесконтрольно используют антисептики, которыми промывают половые органы.
Риск увеличения количества гарднерелл во влагалище повышается при:
- нарушениях менструального цикла
- половых инфекциях, в том числе перенесенных ранее (вылеченных)
- фоновых и предраковых заболеваний цервикса
- длительном использовании оральных контрацептивов
- применении внутриматочной спирали
- недостаточной гигиене половых органов
Количество лактобактерий уменьшается, и у гарднереллы появляется простор для роста.
Их популяция постепенно увеличивается.
Этот процесс происходит медленно, иногда годами.
Гарднереллы продуцируют аминокислоты и летучие кислоты.
Они расщепляются до аминов.
Именно эти соединения вызывают неприятный запах из влагалища – наиболее характерный симптом наличия гарднереллы.
Заболевание гарднерелла
Гарднерелла вызывает заболевание, которое называется бактериальный вагиноз.
В отличие от вагинита, вагиноз не сопровождается воспалительной реакцией.
В мазке не определяются лейкоциты.
Следует заметить, что бактериальный вагиноз может возникать и по причине избыточного роста других условно-патогенных бактерий.
Всего во влагалище обнаруживается до 200 видов таких микробов.
Но среди них гарднерелла встречается наиболее часто.
Этот микроорганизм также является самым патогенным.
Гарднерелла выявляется почти у 100% женщин, имеющих симптомы бактериального вагиноза.
Бактерия продуцирует цитотоксические вещества и адгезины.
На поверхности влагалища она образует пленку.
Женщины нередко спрашивают, это венерологическое заболевание или нет.
В данный момент гарднерелла не считается половой инфекцией.
Потому что симптомы не появляются сразу после заражения.
Гарднерелла может очень долго жить в половых путях, не провоцируя никаких осложнений.
К тому же, влагалищная гарднерелла у женщин даже не вызывает воспалительной реакции.
А вот у мужчин бактерия приобретает свойства половой инфекции.
Представители мужского пола могут заражаться от женщин.
Как уже говорилось, вагинальная трихомонада не живет во рту или в горле.
Но она может поражать репродуктивные органы мужчины.
Источником инфекции является партнерша, страдающая бактериальным вагинозом на момент полового контакта.
В этом случае гарднереллы попадают в уретру.
В большинстве случаев они там не задерживаются.
У 9 мужчин из 10 бактерии погибают уже через несколько дней.
Но в 10% случаев гарднереллы колонизируют половые органы мужчины.
В этом случае развивается гарднереллез.
Он обычно протекает без симптомов.
Тем не менее, при определенных обстоятельствах гарднерелла может вызывать воспалительный процесс в организме мужчины.
Такими обстоятельствами могут быть:
- сопутствующая инфекция урогенитального тракта
- снижение иммунитета
- прием препаратов (антибиотики, иммунодепрессанты, глюкокортикоиды)
- перенесенные тяжелые заболевания, травмы, хирургические операции
Гарднерелла является одним из возбудителей анаэробного баланопостита у мужчин.
Она также может вызывать уретрит.
Может ли вызвать цистит этот микроорганизм?
Воспаление мочевого пузыря гарднереллезной этиологии бывает крайне редко.
Но иногда это происходит.
В таком случае бактерии обнаруживаются в моче.
Описаны также случаи развития простатита, вызванного гарднереллами.
Иногда болезнь может осложняться.
В наиболее тяжелых случаях гарднерелла вызывает:
- синдром Рейтера (реактивное поражение суставов)
- абсцесс легких
- абсцесс околопочечной клетчатки
- сепсис
Как видим, гарднерелла отнюдь не является безобидным микроорганизмом.

О симптомах и лечении
гарднереллеза у мужчин
рассказывает подполковник
медицинской службы, врач
Ленкин Сергей Геннадьевич
Содержание данной статьи проверено и подтверждено на соответствие медицинским
стандартам врачем дерматовенерологом, урологом, к.м.н.
Ленкиным Сергеем Геннадьевичем
Гарднерелла симптомы
При заражении гарднереллой инкубационный период как таковой отсутствует.
Потому что в большинстве случаев микроорганизм не вызывает симптомов вообще.
А если они появляются, то могут возникнуть через годы после заражения.
Основной признак гарднереллеза у женщин – это обильные выделения из влагалища с запахом несвежей рыбы.
Они беспокоят пациентов длительное время.
Выделения могут сохраняться без лечения в течение нескольких лет.
Гарднереллы в мазке
Бактерии могут быть выявлены в мазке на флору.
Гарднерелла вагиналис выглядит как небольшого размера палочки.
Для диагностики заболевания исследование обычно проводится методом ПЦР или с помощью бак посева на микрофлору.
И первый, и второй метод позволяет оценить количественные показатели.
В ходе проведения ПЦР обнаруживается количество копий ДНК в единице объема клинического материала.
Бак посев позволяет оценить соотношение различных видов флоры, обитающей во влагалище женщины.
Гарднерелла норма
В мазке и других анализах гарднерелла может обнаруживаться в норме.
Её пороговая концентрация – 10 в 4 степени.
Такое количество бактерий является показанием к лечению.
Всё что меньше подлежит наблюдению.
Например, если количество бактерий 10 в 3 степени, при отсутствии симптомов лечение врач может не назначить.
Но если популяция гарднерелл возрастает до 10 в 5, 6, 7 и так далее степени, требуется медикаментозная терапия.

Как избавиться от гарднереллы
Гарднереллез имеет неблагоприятные последствия для репродуктивной системы.
Патология вызывает постоянные выделения из влагалища с неприятным запахом.
В результате снижается качество половой жизни.
Гарднерелла нарушает защитный барьер слизистой оболочки влагалища.
Поэтому повышается риск воспалительных заболеваний и венерических инфекций.
Кроме того, существует риск заражения других людей.
Поэтому гарднереллез нужно лечить.
Показанием к лечению является увеличение концентрации микроорганизмов в лабораторных анализах выше нормы или наличие симптомов.
Часто женщины спрашивают, может ли пройти сама гарднерелла, без лечения.
Большинство пациенток годами страдают бактериальным вагинозом.
Симптомы могут быть выражены больше или меньше.
Но самостоятельно биоценоз влагалища обычно не восстанавливается.
Для этого требуется медицинская помощь.
Чтобы избавиться от гарднереллы навсегда, требуется двухэтапная терапия.
Вначале применяются антибиотики для уничтожения патогена.
На втором этапе необходимо заселения влагалища «правильными» микроорганизмами.
К большинству антибиотиков гарднереллы не чувствительны.
Поэтому случайное излечение заболевания во время терапии пневмонии или половых инфекций маловероятно.
Для уничтожения гарднерелл требуются производные 5-нитроимидазола.
К числу этих препаратов относятся:

- метронидазол
- секнидазол
- тинидазол
В некоторой степени эти бактерии также чувствительны к клиндамицину.
Местно можно использовать хлоргексидин.
Курс лечения длится от 2 до 5 дней.
Обычно назначают орнидазол или тинидазол по 0,5 г в день.
В случае рецидива заболевания используется доза препарата 1 г однократно.
Половые партнеры не подлежат лечению.
Исключение составляют случаи, когда у них выявляются гарднереллы или имеются симптомы воспаления урогенитального тракта.
У мужчин лечение ограничивается антибактериальными средствами.
Но у женщин требуется второй этап терапии.
Он состоит в заселении влагалища полезной микрофлорой.
В противном случае гарднереллы снова появятся.
Эубиотики назначают не раньше чем через 3 дня после прекращения приема антибиотиков.
Используются препараты Аципол, Лактобактерин, Лактоген и другие.
Гарднерелла при беременности
Влияние на плод Гарднерелла вагиналис маловероятно.
Пока что не установлено случаев, когда болезнь привела бы к неблагоприятному исходу беременности.
Также инфекция не вызывает воспалительных процессов в организме новорожденного ребенка.
Таким образом, наличие у беременной женщины гарднереллы не является однозначным показанием к лечению.
Терапия проводится лишь в случае наличия симптомов.
Нередко именно во время беременности обостряется гарднереллез.
Причины тому – гормональные изменения и угнетение иммунитета.
Во время беременности может использоваться препарат метронидазол.
Другие лекарственные средства системного действия не применяются, потому что не исключено их токсичное воздействие на плод.
Женщины часто спрашивают, можно ли забеременеть с гарднереллой.
Да, забеременеть можно.
Этот микроорганизм не становится причиной бесплодия напрямую.
Но при этом гарднерелла повышает риск развития воспалительных заболеваний малого таза.
А уже эти патологии способны спровоцировать бесплодие.

Это происходит, если воспаляются обе маточные трубы или слизистая оболочка матки.
Иногда женщины не вынашивают беременность, если она не была желательной, а предпочитают сделать аборт.
В таком случае требуется лечение гарднереллеза даже при отсутствии симптомов.
Чем опасна гарднерелла?
Установлено, что она может вызывать послеоперационные осложнения инфекционного характера.
Поэтому перед кюретажем женщине назначают метронидазол или другой препарат данной группы.
В случае возникновения признаков бактериального вагиноза, обращайтесь в нашу клинику.
Мы проведем диагностику и установим происхождение заболевания.
В случае обнаружения повышенной концентрации гарднерелл вы получите лечение.
Оно позволит нормализовать состав микрофлоры влагалища и избавиться от бактериального вагиноза навсегда.
Читайте также:
